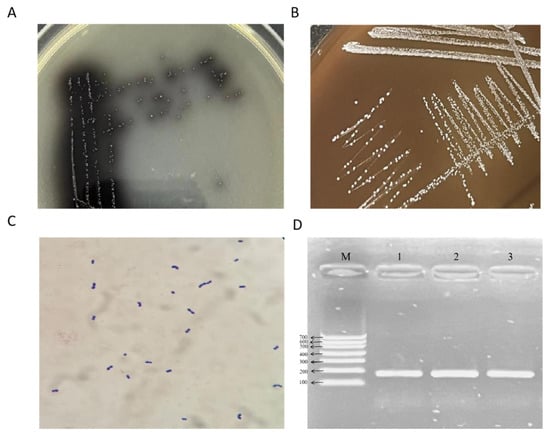

Simple Summary
Antibiotic resistance is a growing problem that threatens both human and animal health. In this study, we investigated bacteria called Enterococcus faecium, which are normally found in the intestines of animals but can sometimes cause serious disease. We collected samples from calves with diarrhea on a cattle farm in Xinjiang, China, and identified three strains of E. faecium. One of these strains was resistant to vancomycin, a very important antibiotic often used as a last resort in hospitals. This resistant strain also carried many genes that help bacteria cause disease, such as those that enable them to stick to host tissues, avoid the immune system, and damage organs. When tested in mice, this strain caused illness and visible damage to the liver and spleen. Our findings show that drug-resistant E. faecium in livestock can pose risks not only to animal health but also to public health, since these strains may spread to humans or the environment. This study highlights the importance of monitoring resistant bacteria in farm animals and developing strategies to reduce their spread, which will help protect both animal farming and society at large.
Abstract
This study aimed to investigate the antimicrobial resistance, virulence gene profile, and pathogenicity of Enterococcus faecium isolated from a large-scale cattle farm in Xinjiang, China, to provide a scientific basis for the prevention and control of E. faecium infections in the region. Nineteen rectal swabs were aseptically collected from diarrheic calves for bacterial isolation. Isolates were identified through morphological observation, biochemical characterization, and PCR amplification. Homology analysis was conducted using 16S rRNA gene sequencing. Antimicrobial susceptibility was evaluated by the disk diffusion method, and key virulence genes were detected using PCR. Pathogenicity was assessed through intraperitoneal inoculation of mice, followed by histopathological examination. Three isolates were identified as E. faecium, consistent with morphological and molecular results. Biochemical tests indicated that the strains could metabolize sucrose, maltose, lactose, melibiose, and raffinose, but not sorbitol. Phylogenetic analysis revealed that isolates SCQ3 and SCQ4 shared 99.3% homology with E. faecium strain MF678878.1, while SCQ11 showed 91% similarity to strain JP2. Antimicrobial susceptibility testing indicated that SCQ11 was resistant to vancomycin. PCR analysis identified the presence of multiple virulence genes, including psaA, hyp, asal, sprE, nuc, cbh, srtA, hyl, scm, and agg. In vivo pathogenicity testing demonstrated that the vancomycin-resistant strain exhibited strong virulence in mice, with gross lesions observed in the liver, spleen, and intestines. Histopathological examination confirmed varying degrees of tissue damage, particularly in the liver and spleen. All three E. faecium isolates exhibited multidrug resistance, with one strain showing vancomycin resistance and harboring a high number of virulent genes. This strain demonstrated significant pathogenicity in vivo. These findings highlight the potential public health threat posed by multidrug-resistant E. faecium in livestock and provide essential data for regional prevention and control strategies.
1. Introduction
Enterococcus faecium is a Gram-positive coccus belonging to the genus Enterococcus that is widely distributed in environmental sources such as soil and water and forms part of the normal gut microbiota of humans and animals [1]. Although many strains are harmless and used as probiotics in both human and veterinary contexts [2,3,4,5], E. faecium has emerged as a significant opportunistic pathogen capable of causing a range of infections in both humans and animals [6].
In livestock systems, particularly in cattle, infection rates of E. faecium are also rising [7]. A major contributing factor is the widespread and sometimes inappropriate use of antibiotics in animal agriculture, which creates selective pressure that favors the survival and spread of resistant strains [8]. This practice has accelerated the emergence of multidrug-resistant (MDR) E. faecium, raising serious concerns about their potential to be transmitted to humans through direct contact, the food chain, or the environment. While some animal-derived E. faecium strains may lack virulence determinants, others carry genetic elements that enhance their ability to cause disease and complicate treatment outcomes [9]. These dynamics underscore the need for ongoing molecular surveillance and robust antibiotic stewardship programs to curb further resistance development [3,10,11].
In recent years, E. faecium has transitioned from a benign commensal organism into a high-risk, MDR hospital-associated pathogen. This transformation is largely attributed to its remarkable genetic plasticity, which allows rapid acquisition of antimicrobial resistance (AMR) genes through mutation and horizontal gene transfer, often via plasmids [12,13,14,15]. Some strains have even been shown to release membrane vesicles containing resistance proteins, further facilitating the spread of resistance [16]. Clinically, E. faecium exhibits both intrinsic resistance to many first-line antibiotics (e.g., cephalosporins, aminoglycosides) and acquired resistance to critical agents like ampicillin [13,14,17,18]. While resistance to linezolid and daptomycin remains less common, it is increasingly reported [19,20]. These resistance genes are frequently plasmid-borne, facilitating their spread across clonal lineages and host species [12,14]. Hospital-adapted E. faecium lineages, such as A1 and ST796, carry numerous resistance and virulence genes and exhibit strong environmental resilience [12,14,21]. Their tolerance to desiccation and disinfectants enables persistence in clinical settings [13,15,22], contributing to nosocomial infections such as bloodstream, urinary tract, and wound infections, especially in immunocompromised patients [15,17,23]. Importantly, E. faecium is also present in livestock, including cattle [5,24,25,26]. In these animals, resistance to critically important antibiotics such as tetracyclines, macrolides, and other antimicrobial classes is frequently observed [25,26,27,28,29,30,31]. Moreover, the occasional overlap in sequence types between bovine and human isolates raises concerns about potential zoonotic transmission or shared reservoirs [30,32,33]. These findings highlight the importance of continued genomic surveillance and careful probiotic use in livestock to minimize public health risks.
Resistance trends in E. faecium vary across regions and over time, shaped by local antibiotic usage and infection control measures [5,11]. As such, molecular surveillance and antibiotic stewardship are critical to limiting the spread of resistant clones [3,10,11].
To better understand the resistance mechanisms and virulence potential of E. faecium in livestock, this study serves as a model investigation. Rectal swabs were collected from diarrheic calves on a large-scale cattle farm in Xinjiang, China. E. faecium strains were isolated, purified, and identified. Antimicrobial susceptibility testing and virulence gene detection were performed, and pathogenicity was evaluated via intraperitoneal inoculation in mice. The results provide a scientific foundation for the prevention and control of E. faecium infections in cattle and contribute to the broader discussion on their impact on public and animal health.
2. Materials and Methods
2.1. Sample Collection and Isolation and Identification of E. faecium
A total of 19 rectal swabs were aseptically collected from diarrheic calves on a cattle farm in Xinjiang Province, China. Swabs were placed in transport media and stored at 4 °C before processing within 24 h. According to the previous procedure [34], each swab was inoculated into brain heart infusion (BHI) broth under sterile conditions and incubated overnight at 37 °C. A small volume of the overnight culture was used for Gram staining and microscopic examination. Cultures were then streaked onto Pfizer enterococcus selective agar plates (Pfizer Inc., Shanghai, China) and incubated at 37 °C for 18–24 h. Colonies appeared as brown/black with brown halos, and the colony morphology was observed and recorded. Typical single colonies from the selective agar plates were picked and sub-cultured in BHI broth, followed by staining and microscopic examination to observe bacterial morphology. The cultures were then streaked onto blood agar plates and incubated at 37 °C for 18–24 h to further assess colony morphology.
Physiological and biochemical identification was performed using bacterial micro biochemical identification tubes (Hope Bio-Technology Co., Ltd., Qingdao, Shandong, China) following Bergey’s Manual of Systematic Bacteriology protocols for Enterococcus species. The strains tested positive for arginine dihydrolase, fermented multiple carbohydrates, hydrolyzed esculin, and showed expected TMZ and DPP positive, MAG and PMG negative reactions, consistent with E. faecium.
Genomic DNA was extracted using the boiling method. PCR amplification of the E. faecium-specific ddl gene was performed using the following primer pair: ddl-F: ACGTTGGATGTCGGCATTACAAAGG and ddl-R: ACGTTGGATGAAGTCGTCCGAACAT, with an expected product size of 176 bp. The PCR reaction mixture consisted of 2 µL DNA template, 1 µL of each forward and reverse primer, 10 µL of 2× Taq PCR Mix, and nuclease-free water to total 20 µL volume. The thermal cycling conditions were as follows: initial denaturation at 95 °C for 30 s; 30 cycles of denaturation at 95 °C for 30 s, annealing at 55 °C for 30 s, and extension at 72 °C for 30 s; followed by a final extension at 72 °C for 10 min and a hold at 4 °C.
For species confirmation, 16S rRNA gene amplification and sequencing were performed using universal primers to yield a ~1500 bp product [35]. PCR products were gel-purified and sequenced using Sanger sequencing. The obtained sequences were subjected to BLAST+ 2.16.0 analysis against the NCBI nucleotide database to assess sequence similarity. A phylogenetic tree was constructed based on the aligned 16S rRNA sequences to evaluate genetic relationships among isolates using MEGA 10 software and the neighbor-joining method with 1000 bootstrap replicates.
Three strains were selected from the isolated and purified Enterococcus faecalis strains for subsequent pathogenicity testing. The selection criteria were as follows: From 19 rectal swab samples, these three strains were isolated from three calves with typical clinical signs of diarrhea (defined as ≥3 watery fecal episodes per day) and no other co-infections. Additionally, the colony detection density of these strains on selective agar plates was significantly higher than that of other isolates at the time of isolation.
2.2. Antimicrobial Susceptibility Testing
Antimicrobial susceptibility was tested for SCQ3, SCQ4, and SCQ11 using the Kirby–Bauer disk diffusion method, following the guidelines of the Clinical and Laboratory Standards Institute [36]. A total of 14 antibiotics were tested: azithromycin (15 µg), streptomycin (10 µg), roxithromycin (30 µg), vancomycin (30 µg), kanamycin (30 µg), gentamicin (10 µg), tetracycline (30 µg), enrofloxacin (5 µg), ciprofloxacin (5 µg), nitrofurantoin (300 µg), cefotaxime sodium (30 µg), oxacillin (1 µg), chloramphenicol (30 µg), and sulfadiazine (300 µg). The antimicrobial resistance profiles of the isolates were determined based on the diameters of the inhibition zones, as interpreted according to CLSI standards [36]. Quality control strain E. faecalis ATCC 29212 was used.
2.3. Virulence Gene Detection
PCR was used to detect the presence of virulence genes including psaA, hyp, asal, sprE, nuc, cbh, srtA, hyl, scm, ace, and agg. The primer sequences and expected amplicon sizes are listed in Table 1. The PCR conditions were as follows: initial denaturation at 95 °C for 5 min; followed by 30 cycles of denaturation at 95 °C for 30 s, annealing at 55 °C for 35 s, and extension at 72 °C for 45 s; with a final extension at 72 °C for 10 min. Amplified products were separated by electrophoresis on a 1% agarose gel at 120 V for 30 min and visualized using a gel imaging system were visualized under UV after staining with ethidium bromide. Positive controls for each virulence gene and nuclease-free water as negative control were included. Bands were compared to a 100 bp DNA ladder.
Table 1.
Primer sequences and amplicon sizes.
2.4. Animal Pathogenicity Assay
The animal study protocol was approved by the Biology Ethics Committee of Shihezi University in March 2024 (A2024-136).
Ten C57BL/6 mice (6–8 weeks old) were randomly divided into two groups (n = 5 per group). Mice in the experimental group were intraperitoneally inoculated with 0.2 mL of the bacterial suspension, while those in the control group received an equal volume of sterile PBS. Clinical symptoms and survival were monitored for 72 h. At the end of the experiment or upon death, liver, spleen, and intestines were aseptically harvested. Bacteria were re-isolated, and E. faecium was confirmed via ddl PCR (176 bp product) using 2× Taq PCR Master Mix (Tiangen Biotech Co., Ltd., Beijing, China). Tissues were fixed in 10% formalin, embedded in paraffin, sectioned at 5 µm, and stained with Hematoxylin and Eosin (H&E). Lesions were assessed under light microscopy.
2.5. Statistical Analysis
Descriptive analysis was used to interpret antimicrobial susceptibility profiles based on inhibition zone diameters for individual isolates. Sensitivity classifications were assigned according to Clinical and Laboratory Standards Institute criteria [36]. For virulence gene detection and biochemical test results, presence or absence was recorded descriptively. Pathogenic outcomes, including clinical observations and histopathological findings, were qualitatively compared between groups. Statistical testing was not applied due to the categorical nature of the data.
3. Results
3.1. Isolation and Identification Pathogenic Strains of E. faecium
A total of three pathogenic E. faecium strains were isolated from 19 collected samples. After overnight incubation in BHI broth, smears of the cultures were subjected to Gram staining, which revealed numerous Gram-positive cocci under microscopic examination. When streaked onto Enterococcus-selective agar, the isolates produced brown-black colonies surrounded by brown halos (Figure 1A). On blood agar plates, the colonies appeared as small, round, slightly raised, grayish-white, translucent colonies with smooth and moist surfaces (Figure 1B). Gram staining again confirmed that all isolates were Gram-positive cocci, occurring singly or in pairs (Figure 1C).
Figure 1.
Identification and molecular characterization of E. faecium isolates. (A) Colony morphology on Enterococcus-selective agar showing brown-black colonies with brown halos. (B) Colony morphology on blood agar with small, round, slightly raised, grayish-white, translucent colonies. (C) Gram staining showing Gram-positive cocci, occurring singly or in pairs. (D) PCR amplification of the ddl gene showing a 176 bp product specific to E. faecium; Lanes 1–3 in correspond to isolates SCQ3, SCQ4, and SCQ11, respectively. (E) 16S rRNA gene amplification producing an approximately 1500 bp band; Lanes 1–3 in correspond to isolates to SCQ3, SCQ4, and SCQ11, respectively. (F) Neighbor-joining phylogenetic tree constructed using MEGA X from aligned 16S rRNA sequences, illustrating genetic relationships between isolates and reference E. faecium strains from NCBI. Bootstrap values (n = 1000 replicates) shown at branches; scale bar indicates evolutionary distance.
Colony morphology and staining results were consistent with typical E. faecium characteristics. PCR amplification targeting the E. faecium-specific ddl gene produced a clear band of approximately 176 bp (Figure 1D). Lanes 1–3 in Figure 1D correspond to isolates SCQ3, SCQ4, and SCQ11, respectively. Amplification using universal 16S rRNA primers yielded a product of approximately 1500 bp (Figure 1E). Lanes 1–3 in Figure 1E also correspond to SCQ3, SCQ4, and SCQ11.
The amplified 16S rRNA fragments were gel-purified and sequenced. Sequence analysis revealed that isolates SCQ3 and SCQ4 shared 100% sequence identity and were therefore considered the same strain. SCQ3/SCQ4 showed 99.3% sequence similarity to strain MF678878.1 and clustered in the same phylogenetic branch. Isolate SCQ11 exhibited 91% similarity with strain JP2 and grouped within the same branch (Figure 1F). The phylogenetic tree confirmed the genetic relatedness of the isolates to known E. faecium strains, validating their identification.
The biochemical identification results of the isolates are shown in Table 2. The strains tested positive for the arginine dihydrolase test and were able to ferment fructose, melibiose, xylose, trehalose, maltose, glucose, lactose, sucrose, and raffinose, but not sorbitol. They were also capable of hydrolyzing esculin. Positive reactions were observed in TMZ and DPP tests, while MAG and PMG tests were negative. These results are consistent with the biochemical characteristics of Enterococcus faecium. All three isolates exhibited a similar biochemical profile consistent with E. faecium, further supporting the molecular identification.
Table 2.
Biochemical identification results of E. faecium isolates.
3.2. Antimicrobial Susceptibility Testing of Isolates
Antimicrobial susceptibility testing was conducted for isolates SCQ3, SCQ4, and SCQ11. The results showed that SCQ3 was highly sensitive to azithromycin, roxithromycin, vancomycin, nitrofurantoin, and chloramphenicol, and moderately sensitive to enrofloxacin and tetracycline. SCQ4 exhibited extreme sensitivity to vancomycin and nitrofurantoin, high sensitivity to azithromycin, roxithromycin, enrofloxacin, and chloramphenicol, and moderate sensitivity to tetracycline. In contrast, SCQ11 showed high sensitivity only to nitrofurantoin and moderate sensitivity to azithromycin but was not sensitive to vancomycin or most other antibiotics tested. These results indicate a varied AMR pattern among the three isolates, with SCQ11 exhibiting a broader resistance profile compared to SCQ3 and SCQ4. The detailed antimicrobial susceptibility profiles are presented in Table 3.
Table 3.
Diameter of inhibition zones (mm) of three E. faecium isolates against tested antibiotics.
3.3. Virulence Gene Detection in Vancomycin-Resistant Isolate SCQ11
PCR was used to detect the presence of 11 major virulence genes in the vancomycin-resistant strain SCQ11. As shown in Figure 2, a total of 10 virulence genes were detected, including psaA, hyp, asal, sprE, nuc, cbh, srtA, hyl, scm, and agg. The ace gene was not detected. These findings demonstrate that SCQ11 harbors a broad array of virulence-associated genes in addition to extensive antimicrobial resistance, underscoring its clinical significance as a multidrug-resistant pathogen.
Figure 2.
PCR amplification results for virulence gene detection in E. faecium isolates. M: DNA ladder (100 bp marker); Lanes 1–11: PCR amplicons for virulence genes. 1: psaA gene; 2: hyp gene; 3: asal gene; 4: sprE; 5: nuc gene; 6: cbh gene; 7: srtA gene; 8: hyl gene; 9: scm gene; 10: ace gene (not detected); 11: agg gen. Bands indicate the presence of the corresponding gene.
3.4. Pathogenicity Assessment of Vancomycin-Resistant Isolate SCQ11
Mouse infection experiments revealed that mice in the experimental group exhibited varying degrees of lethargy piloerection, and reduced activity. Postmortem examination revealed congestion and hemorrhaging in the liver and spleen, along with swelling in the liver, spleen, and intestinal tissues. Tissue samples from deceased mice were aseptically inoculated into liquid culture media, and bacterial isolation and identification confirmed the presence of E. faecium. PCR using E. faecium-specific primers yielded the expected 176 bp product (Figure 3A). Histopathological analysis of infected liver and spleen revealed hemorrhagic lesions in both the liver and spleen and distinct pathological alterations, including disorganized hepatic architecture with hemorrhagic foci and splenic tissue damage with lymphocyte depletion and hemorrhage (Figure 3B,C).
Figure 3.
Pathogenicity assessment of E. faecium isolate SCQ11 in mice. (A) PCR electrophoresis of enterococci-specific primers targeting the ddl gene (176 bp) in tissue samples from infected mice. M: DNA ladder; Lanes 1–6: 1: liver 1; 2: intestine; 3: brain; 4: spleen 1; 5: liver 2; 6: spleen 2. (B) H&E-stained liver section from an infected mouse showing congestion and cellular disorganization (40×). (C) H&E-stained spleen section from an infected mouse showing disruption of normal architecture and hemorrhagic infiltration (40×).
4. Discussion
E. faecium is a common member of the normal intestinal microbiota in both humans and animals [1,8], and certain strains have been used as probiotics due to their ability to inhibit pathogenic bacteria and enhance host immune function [2,3,4,5]. For example, it was reported that dietary supplementation with 1 × 107 CFU/kg E. faecium for 28 days in mid-lactation Holstein dairy cows reduced lactate dehydrogenase levels, increased antitumor factor concentrations and red blood cell counts, and improved cellular immune responses [37]. However, under immunocompromised conditions, E. faecium may act as an opportunistic pathogen [6], translocating from the intestinal tract to other organs where it adheres, aggregates, and initiates infection [20,38,39], leading to serious diseases such as bacteremia and endocarditis [40]. Since the 1990s, enterococci have increasingly been recognized as significant opportunistic pathogens in both humans and animals, with infection cases rising annually [8]. The widespread misuse and overuse of antibiotics has further contributed to the emergence of drug-resistant strains.
In this study, three pathogenic E. faecium strains (SCQ3, SCQ4, and SCQ11) were isolated from rectal swabs of diarrheic calves on a cattle farm in Xinjiang Province, China. A limitation of this study is that strain isolation was conducted at a single location, which may restrict the representativeness of the samples. Therefore, future studies involving multiple geographic regions and larger sample sizes are needed to better understand the distribution, epidemiological significance, and broader impact of E. faecium in cattle populations. However, the core objective of this study was to validate the expression of specific virulence genes and the in vitro pathogenicity of the target pathogen, not to statistically determine the infection rate across different cattle populations. From these samples, the three selected strains were isolated from three calves with typical clinical signs of diarrhea (defined as ≥3 watery fecal episodes per day) and no other co-infections. Additionally, the colony detection density of these strains on selective agar plates was significantly higher than that of other isolates at the time of isolation. These strains were identified through Gram staining, biochemical profiling, and 16S rRNA PCR amplification. The use of combined morphological, biochemical, and molecular techniques minimized misidentification and confirmed the isolates as E. faecium. Phylogenetic analysis based on 16S rRNA sequences revealed that SCQ3 and SCQ4 shared 99.3% sequence identity with strain MF678878.1 and clustered in the same branch, while SCQ11 exhibited 91% similarity to strain JP2 and formed a separate cluster.
The pathogenicity of E. faecium is largely attributed to its resistance to multiple antibiotics and the presence of virulence genes [8]. Multidrug resistance makes treatment of E. faecium infections particularly challenging [41]. Therefore, determining the susceptibility profile is essential for guiding appropriate antimicrobial therapy [15]. In this study, antimicrobial susceptibility testing showed that SCQ3 was highly sensitive to azithromycin, roxithromycin, vancomycin, nitrofurantoin, and chloramphenicol; SCQ4 exhibited extreme sensitivity to vancomycin and nitrofurantoin, and high sensitivity to azithromycin, roxithromycin, enrofloxacin, and chloramphenicol. In contrast, SCQ11 was only highly sensitive to nitrofurantoin and moderately sensitive to azithromycin and was resistant to vancomycin and most other antibiotics. All three isolates demonstrated multidrug resistance, which may be associated with long-term or improper use of antibiotics on the farm, leading to compromised host immunity and increased pathogen virulence.
These findings are consistent with the well-documented trend of E. faecium acquiring multidrug resistance, particularly in agricultural settings where antibiotics may be used routinely or inappropriately [42,43]. The resistance profile of SCQ11, which includes vancomycin and multiple other antibiotic classes, raises concern about the potential for zoonotic transmission of resistant strains. Studies have shown that such resistance is often mediated by mobile genetic elements like plasmids and transposons, facilitating horizontal gene transfer across strains and host species [12,44]. The susceptibility of SCQ3 and SCQ4 to key antibiotics may reflect limited prior exposure or recent introduction into the farm environment, while SCQ11’s broader resistance could suggest a longer adaptation period or acquisition of resistance determinants through selective pressure. These patterns emphasize the importance of antimicrobial stewardship in livestock to prevent the emergence and dissemination of resistant E. faecium strains with enhanced pathogenic potential. The emergence of vancomycin-resistant Enterococcus strains (VRE) in livestock poses a significant public health threat, as these findings underscore a critical **One Health** concern where the health of animals and humans are inextricably linked. The potential for these resistant strains to be transmitted from livestock to humans—either directly through farm workers or indirectly via the food chain and environmental contamination—is well-documented. This transmission pathway compromises the efficacy of vancomycin, a last-resort antibiotic for treating severe human infections, particularly those caused by multidrug-resistant Gram-positive bacteria. Addressing this challenge requires an integrated, multi-sectoral approach that includes veterinary medicine, human medicine, and environmental science to implement robust antimicrobial stewardship programs [45,46,47,48].
In addition to antibiotic resistance, the pathogenicity of E. faecium is also closely linked to its acquisition of virulence genes [49]. These genes play a key role in the infectious process. Known virulence factors in Enterococcus species include the enterococcal surface protein gene (esp), which facilitates adhesion and biofilm formation; hyaluronidase gene (hyl), which degrades host connective tissue and aids dissemination; collagen-binding adhesin gene (ace), which promotes binding to extracellular matrix proteins; gelatinase gene (gelE), which hydrolyzes host proteins; cytolysin gene (cyl), which contributes to hemolysis and tissue damage [50]; and aggregation substance gene (asa1), and collagen adhesion protein gene (agg), which enhance intercellular adherence and plasmid transfer, promoting pathogenicity and resistance spread [51]. In this study, 10 virulence genes, psaA, hyp, asal, sprE, nuc, cbh, srtA, hyl, scm, and agg, were detected in the vancomycin-resistant isolate SCQ11; only the ace gene was not detected. Pathogenicity testing in mice revealed that SCQ11 had strong virulence, which may be due to the high number of virulence genes and potential synergistic effects among them. The detection of 10 virulent genes in the SCQ11 strain highlights its strong pathogenic potential. Genes such as hyl (involved in tissue degradation), sprE and nuc (involved in immune evasion), and agg (promoting adhesion and biofilm formation) may act synergistically to enhance colonization, invasion, and persistence in the host [49,51]. The absence of the ace gene, a collagen-binding protein commonly associated with endocarditis and urinary tract infections, may indicate a different pathogenic strategy in SCQ11, potentially favoring bloodstream or intestinal colonization routes. The presence of such a broad virulence repertoire, particularly in a vancomycin-resistant background, raises concern for zoonotic transmission and highlights the strain’s public health relevance. These genes are likely to contribute not only to disease severity but also to resistance to host immune clearance mechanisms. Moreover, the co-presence of multiple virulence genes and vancomycin resistance in SCQ11 suggests a concerning convergence of antimicrobial resistance and pathogenic potential. The ability of E. faecium to simultaneously harbor genes like agg, hyl, srtA, and scm, which are involved in adhesion, immune evasion, and tissue invasion, may enhance its fitness and adaptability in the host environment [17]. This combination is particularly alarming in the context of animal–human transmission, as it increases the likelihood that multidrug-resistant and virulent strains can colonize and infect immuno-compromised hosts. Several studies have suggested that virulence and resistance determinants may be co-selected through shared mobile genetic elements or induced under antibiotic pressure [44]. These findings underscore the need for integrated surveillance of both resistance and virulence traits in livestock-associated enterococcal populations to inform risk assessments and containment strategies.
5. Conclusions
This study successfully isolated and identified three E. faecium strains (SCQ3, SCQ4, and SCQ11) from diarrheic calves using bacteriological and molecular methods. Their antimicrobial resistance and pathogenicity were characterized, providing foundational data for future prevention and control strategies targeting E. faecium. With the continuous increase in virulence and resistance of E. faecium, its threat to animal husbandry is becoming more serious [52]. Further research is needed to elucidate the mechanisms underlying antibiotic resistance and virulent gene expression, which will be critical for developing effective strategies to mitigate E. faecium-associated infections in both animals and humans.
Author Contributions
Conceptualization, Y.Q. and F.D.; Methodology, M.C., F.C. and F.D.; Software, C.W.; Validation, M.C., F.C. and X.Y.; Formal Analysis, M.C.; Investigation, M.C., F.C., C.W., S.Z. and X.Y.; Resources, Y.Q. and Y.W.; Data Curation, M.C.; Writing—Original Draft Preparation, M.C. and F.C.; Writing—Review and Editing, F.D., S.A., L.Y., S.Z., A.M.A. and Y.W.; Visualization, C.W.; Supervision, Y.Q. and Y.W.; Project Administration, Y.Q.; Funding Acquisition, Y.Q., M.C. and F.C. contributed equally to this work. All authors have read and agreed to the published version of the manuscript.
Funding
This study was financially supported by the National Natural Science Foundation of China (Grant No. 32460898), the Science and Technology Achievement Transformation Project of Shihezi University (Grant No. CGZH202104), and the Agricultural Key Core Technology Tackling Project of Xinjiang Production and Construction Corps (Grant No. 2023AA310).
Institutional Review Board Statement
The animal study protocol was approved by the Biology Ethics Committee of Shihezi University in March 2024 (A2024-136).
Informed Consent Statement
Not applicable.
Data Availability Statement
The original contributions presented in this study are included in the article. Further inquiries can be directed to the corresponding authors.
Conflicts of Interest
The authors declare no conflicts of interest.
Correction Statement
This article has been republished with a minor correction to the Funding statement. This change does not affect the scientific content of the article.
Abbreviations
| 16S rRNA | 16S Ribosomal Ribonucleic Acid |
| ace | Adhesin to Collagen of Enterococcus |
| agg | Aggregation Substance |
| AMR | Antimicrobial Resistance |
| asa1 | Aggregation Substance Gene |
| asal | Aggregation Substance Associated Lipoprotein |
| ATCC | American Type Culture Collection |
| BHI | Brain Heart Infusion |
| cbh | Cell-Binding Homolog |
| cyl | Cytolysin Gene |
| CFU/kg | Colony-Forming Units per Kilogram |
| CLSI | Clinical and Laboratory Standards Institute |
| esp | Enterococcal Surface Protein Gene |
| E. faecium | Enterococcus faecium |
| gelE | Gelatinase Gene |
| H&E | Hematoxylin and Eosin |
| hyl | Hyaluronidase |
| hyp | Hypothetical Protein (unknown function) |
| MAG | Mannose Agar Gel Test |
| MDR | Multidrug-Resistant |
| nuc | Nuclease |
| NCBI | National Center for Biotechnology Information |
| PBS | Phosphate-Buffered Saline |
| PMG | Phenol-Mannitol Gel Test |
| PCR | Polymerase Chain Reaction |
| psaA | Pneumococcal Surface Adhesin A |
| SCQ3, SCQ4, SCQ11 | Strain Codes for E. faecium Isolates |
| scm | Surface Protein (Collagen-binding Adhesin) |
| sprE | Serine Protease |
| srtA | Sortase A (anchors surface proteins to cell wall) |
| TMZ | Tryptone-Mannitol-Zinc Test |
| UV | Ultraviolet |
References
- Aziz, F.; Khan, M.N.; Ahmed, S.; Andrews, S.C. Draft Genome Sequence of Enterococcus faecium SP15, a Potential Probiotic Strain Isolated from Spring Water. BMC Res. Notes 2019, 12, 99. [Google Scholar] [CrossRef]
- Klare, I.; Konstabel, C.; Badstübner, D.; Werner, G.; Witte, W. Occurrence and Spread of Antibiotic Resistances in Enterococcus faecium. Int. J. Food Microbiol. 2003, 88, 269–290. [Google Scholar] [CrossRef]
- Torres, C.; Alonso, C.A.; Ruiz-Ripa, L.; León-Sampedro, R.; Del Campo, R.; Coque, T.M. Antimicrobial Resistance in Enterococcus spp. of Animal Origin. Microbiol. Spectr. 2018, 6, ARBA-0032-2018. [Google Scholar] [CrossRef]
- Xuan, H.; Yao, X.; Pan, R.; Gao, Y.; Wei, J.; Shao, D.; Liu, K.; Li, Z.; Qiu, Y.; Ma, Z.; et al. Antimicrobial Resistance in Enterococcus faecium and Enterococcus faecalis Isolates of Swine Origin from Eighteen Provinces in China. J. Vet. Med. Sci. 2021, 83, 1952–1958. [Google Scholar] [CrossRef]
- Zaheer, R.; Cook, S.R.; Barbieri, R.; Goji, N.; Cameron, A.; Petkau, A.; Polo, R.O.; Tymensen, L.; Stamm, C.; Song, J.; et al. Surveillance of Enterococcus spp. Reveals Distinct Species and Antimicrobial Resistance Diversity across a One-Health Continuum. Sci. Rep. 2020, 10, 3937. [Google Scholar] [CrossRef] [PubMed]
- Im, E.J.; Lee, H.H.-Y.; Kim, M.; Kim, M.-K. Evaluation of Enterococcal Probiotic Usage and Review of Potential Health Benefits, Safety, and Risk of Antibiotic-Resistant Strain Emergence. Antibiotics 2023, 12, 1327. [Google Scholar] [CrossRef]
- Krawczyk, B.; Wityk, P.; Gałęcka, M.; Michalik, M. The Many Faces of Enterococcus spp.—Commensal, Probiotic and Opportunistic Pathogen. Microorganisms 2021, 9, 1900. [Google Scholar] [CrossRef] [PubMed]
- Ferchichi, M.; Sebei, K.; Boukerb, A.M.; Karray-Bouraoui, N.; Chevalier, S.; Feuilloley, M.G.J.; Connil, N.; Zommiti, M. Enterococcus spp.: Is It A Bad Choice A Good Use—A Conundrum Solve? Microorganisms 2021, 9, 2222. [Google Scholar] [CrossRef] [PubMed]
- Seputiene, V.; Bogdaite, A.; Ruzauskas, M.; Suziedeliene, E. Antibiotic Resistance Genes and Virulence Factors in Enterococcus faecium and Enterococcus faecalis from Diseased Farm Animals: Pigs, Cattle and Poultry. Pol. J. Vet. Sci. 2012, 15, 431–438. [Google Scholar]
- Huang, C.; Moradi, S.; Sholeh, M.; Tabaei, F.M.; Lai, T.; Tan, B.; Meng, J.; Azizian, K. Global Trends in Antimicrobial Resistance of Enterococcus faecium: A Systematic Review and Meta-Analysis of Clinical Isolates. Front. Pharmacol. 2025, 16, 1505674. [Google Scholar] [CrossRef]
- Markwart, R.; Willrich, N.; Haller, S.; Noll, I.; Koppe, U.; Werner, G.; Eckmanns, T.; Reuss, A. The Rise in Vancomycin-Resistant Enterococcus faecium in Germany: Data from the German Antimicrobial Resistance Surveillance (ARS). Antimicrob. Resist. Infect. Control 2019, 8, 147. [Google Scholar] [CrossRef]
- Arredondo-Alonso, S.; Top, J.; McNally, A.; Puranen, S.; Pesonen, M.; Pensar, J.; Marttinen, P.; Braat, J.C.; Rogers, M.R.C.; Van Schaik, W.; et al. Plasmids Shaped the Recent Emergence of the Major Nosocomial Pathogen Enterococcus faecium. mBio 2020, 11, e03284-19. [Google Scholar] [CrossRef]
- García-Solache, M.; Rice, L.B. The Enterococcus: A Model of Adaptability to Its Environment. Clin. Microbiol. Rev. 2019, 32, e00058-18. [Google Scholar] [CrossRef]
- Guzman Prieto, A.M.; Van Schaik, W.; Rogers, M.R.C.; Coque, T.M.; Baquero, F.; Corander, J.; Willems, R.J.L. Global Emergence and Dissemination of Enterococci as Nosocomial Pathogens: Attack of the Clones? Front. Microbiol. 2016, 7, 788. [Google Scholar] [CrossRef]
- Wei, Y.; Palacios Araya, D.; Palmer, K.L. Enterococcus faecium: Evolution, Adaptation, Pathogenesis and Emerging Therapeutics. Nat. Rev. Microbiol. 2024, 22, 705–721. [Google Scholar] [CrossRef]
- Wagner, T.; Joshi, B.; Janice, J.; Askarian, F.; Škalko-Basnet, N.; Hagestad, O.C.; Mekhlif, A.; Wai, S.N.; Hegstad, K.; Johannessen, M. Enterococcus faecium Produces Membrane Vesicles Containing Virulence Factors and Antimicrobial Resistance Related Proteins. J. Proteom. 2018, 187, 28–38. [Google Scholar] [CrossRef] [PubMed]
- Arias, C.A.; Murray, B.E. The Rise of the Enterococcus: Beyond Vancomycin Resistance. Nat. Rev. Microbiol. 2012, 10, 266–278. [Google Scholar] [CrossRef] [PubMed]
- Cattoir, V.; Giard, J.-C. Antibiotic Resistance in Enterococcus faecium Clinical Isolates. Expert Rev. Anti Infect. Ther. 2014, 12, 239–248. [Google Scholar] [CrossRef]
- Lee, T.; Pang, S.; Abraham, S.; Coombs, G.W. Antimicrobial-Resistant CC17 Enterococcus faecium: The Past, the Present and the Future. J. Glob. Antimicrob. Resist. 2019, 16, 36–47. [Google Scholar] [CrossRef]
- Yim, J.; Smith, J.R.; Rybak, M.J. Role of Combination Antimicrobial Therapy for Vancomycin-Resistant Enterococcus faecium Infections: Review of the Current Evidence. Pharmacother. J. Hum. Pharmacol. Drug Ther. 2017, 37, 579–592. [Google Scholar] [CrossRef]
- Gao, W.; Howden, B.P.; Stinear, T.P. Evolution of Virulence in Enterococcus faecium, a Hospital-Adapted Opportunistic Pathogen. Curr. Opin. Microbiol. 2018, 41, 76–82. [Google Scholar] [CrossRef]
- Zhou, X.; Willems, R.J.L.; Friedrich, A.W.; Rossen, J.W.A.; Bathoorn, E. Enterococcus faecium: From Microbiological Insights to Practical Recommendations for Infection Control and Diagnostics. Antimicrob. Resist. Infect. Control 2020, 9, 130. [Google Scholar] [CrossRef] [PubMed]
- Gouliouris, T.; Coll, F.; Ludden, C.; Blane, B.; Raven, K.E.; Naydenova, P.; Crawley, C.; Török, M.E.; Enoch, D.A.; Brown, N.M.; et al. Quantifying Acquisition and Transmission of Enterococcus faecium Using Genomic Surveillance. Nat. Microbiol. 2020, 6, 103–111. [Google Scholar] [CrossRef] [PubMed]
- Cebeci, T. Species Prevalence, Virulence Genes, and Antibiotic Resistance of Enterococci from Food-Producing Animals at a Slaughterhouse in Turkey. Sci. Rep. 2024, 14, 13191. [Google Scholar] [CrossRef]
- Messele, Y.; Hasoon, M.; Trott, D.; Veltman, T.; McMeniman, J.; Kidd, S.; Low, W.; Petrovski, K. Longitudinal Analysis of Antimicrobial Resistance among Enterococcus Species Isolated from Australian Beef Cattle Faeces at Feedlot Entry and Exit. Animals 2022, 12, 2690. [Google Scholar] [CrossRef]
- Ocejo, M.; Mugica, M.; Oporto, B.; Lavín, J.L.; Hurtado, A. Whole-Genome Long-Read Sequencing to Unveil Enterococcus Antimicrobial Resistance in Dairy Cattle Farms Exposed a Widespread Occurrence of Enterococcus lactis. Microbiol. Spectr. 2024, 12, e03672-23. [Google Scholar] [CrossRef]
- Beukers, A.G.; Zaheer, R.; Goji, N.; Amoako, K.K.; Chaves, A.V.; Ward, M.P.; McAllister, T.A. Comparative Genomics of Enterococcus spp. Isolated from Bovine Feces. BMC Microbiol. 2017, 17, 52. [Google Scholar] [CrossRef] [PubMed]
- Brotto, A.L.C.; Silva, S.V.; Silva, R.L.S.; Antoniazzi, F.B.; Stievano, J.M.; Nakaghi, A.C.H.; Barberato-Filho, S.; Silva, M.T.; Bergamaschi, C.C. Prevalence of antimicrobial-resistant Enterococcus faecium in commercial cattle: A systematic review and meta-analysis. Ars Vet. 2022, 38, 57. [Google Scholar] [CrossRef]
- Makarov, D.A.; Ivanova, O.E.; Pomazkova, A.V.; Egoreva, M.A.; Prasolova, O.V.; Lenev, S.V.; Gergel, M.A.; Bukova, N.K.; Karabanov, S.Y. Antimicrobial Resistance of Commensal Enterococcus faecalis and Enterococcus faecium from Food-Producing Animals in Russia. Vet. World 2022, 15, 611–621. [Google Scholar] [CrossRef]
- Messele, Y.E.; Trott, D.J.; Hasoon, M.F.; Veltman, T.; McMeniman, J.P.; Kidd, S.P.; Petrovski, K.R.; Low, W.Y. Phylogeny, Virulence, and Antimicrobial Resistance Gene Profiles of Enterococcus faecium Isolated from Australian Feedlot Cattle and Their Significance to Public and Environmental Health. Antibiotics 2023, 12, 1122. [Google Scholar] [CrossRef]
- Zaidi, S.-Z.; Zaheer, R.; Poulin-Laprade, D.; Scott, A.; Rehman, M.A.; Diarra, M.; Topp, E.; Domselaar, G.V.; Zovoilis, A.; McAllister, T.A. Comparative Genomic Analysis of Enterococci across Sectors of the One Health Continuum. Microorganisms 2023, 11, 727. [Google Scholar] [CrossRef]
- Cinthi, M.; Coccitto, S.N.; Simoni, S.; Vignaroli, C.; Brenciani, A.; Giovanetti, E. An Enterococcus faecium Isolated from Bovine Feces in Italy Shares optrA- and poxtA-Carrying Plasmids with Enterococci from Switzerland. Microb. Drug Resist. 2023, 29, 438–442. [Google Scholar] [CrossRef]
- Lopes, J.; De Lencastre, H.; Conceição, T. Genomic Analysis of Enterococcus faecium from Non-Clinical Settings: Antimicrobial Resistance, Virulence, and Clonal Population in Livestock and the Urban Environment. Front. Microbiol. 2024, 15, 1466990. [Google Scholar] [CrossRef]
- Nurrahmat, A.M.I.; Susetya, H.; Putri, K. Antibiogram Profile of Enterococcus faecalis and Enterococcus faecium in Chicken Meat from Supermarkets in Sleman District, Indonesia. Vet. World 2025, 18, 491–499. [Google Scholar] [CrossRef]
- Ryu, H.; Henson, M.; Elk, M.; Toledo-Hernandez, C.; Griffith, J.; Blackwood, D.; Noble, R.; Gourmelon, M.; Glassmeyer, S.; Santo Domingo, J.W. Development of Quantitative PCR Assays Targeting the 16S rRNA Genes of Enterococcus spp. and Their Application to the Identification of Enterococcus Species in Environmental Samples. Appl. Environ. Microbiol. 2013, 79, 196–204. [Google Scholar] [CrossRef] [PubMed]
- Clinical & Laboratory Standards Institute. M100-Performance Standards for Antimicrobial Susceptibility Testing, 28th ed.; Clinical & Laboratory Standards Institute: Wayne, PA, USA, 2018; Available online: https://fda.report/Standards/37761 (accessed on 1 August 2025).
- Qiaoyun, X.; Mengzhi, W.; Yongjiu, H.; Yuhong, L. Effects of Enterococcus faecium Preparation on Serum Biochemical, Antioxidant, and Immune Indices in Mid-Lactation Dairy Cows. Feed Ind. 2018, 39, 22–29. [Google Scholar]
- Fengqin, W.; Haitao, X.; Baocheng, H.; Xiaoyong, X.; Shijun, B.; Yonghao, H. Isolation, Identification, and Biological Characterization of Enterococcus faecium from Sheep. Chin. J. Vet. Med. Herb. Med. 2020, 39, 13–16. [Google Scholar]
- Tiantian, B.; Xuefeng, G. Characteristics of Enterococcus faecium and Research Progress on Its Application in Livestock Production. China Anim. Husb. J. 2021, 57, 16–20. [Google Scholar]
- Pengjuan, G. Isolation and Identification of Enterococcus faecium Phage IME-EFm5 and Study on the Key Functional Sites of Its Endolysin. Ph.D. Thesis, Jilin University, Changchun, China, 2016. [Google Scholar]
- Radford-Smith, D.E.; Anthony, D.C. Vancomycin-Resistant, E. faecium: Addressing Global and Clinical Challenges. Antibiotics 2025, 14, 522. [Google Scholar] [CrossRef]
- Economou, V.; Gousia, P. Agriculture and Food Animals as a Source of Antimicrobial-Resistant Bacteria. Infect. Drug Resist. 2015, 8, 49–61. [Google Scholar] [CrossRef]
- Ghosh, S.; LaPara, T.M. The Effects of Subtherapeutic Antibiotic Use in Farm Animals on the Proliferation and Persistence of Antibiotic Resistance among Soil Bacteria. ISME J. 2007, 1, 191–203. [Google Scholar] [CrossRef]
- Hegstad, K.; Mikalsen, T.; Coque, T.M.; Werner, G.; Sundsfjord, A. Mobile Genetic Elements and Their Contribution to the Emergence of Antimicrobial Resistant Enterococcus faecalis and Enterococcus faecium. Clin. Microbiol. Infect. 2010, 16, 541–554. [Google Scholar] [CrossRef]
- Ahmad, N.; Joji, R.M.; Shahid, M. Evolution and Implementation of One Health to Control the Dissemination of Antibiotic-Resistant Bacteria and Resistance Genes: A Review. Front. Cell. Infect. Microbiol. 2023, 12, 1065796. [Google Scholar] [CrossRef]
- Hibbard, R.; Mendelson, M.; Page, S.W.; Ferreira, J.P.; Pulcini, C.; Paul, M.C.; Faverjon, C. Antimicrobial Stewardship: A Definition with a One Health Perspective. Npj Antimicrob. Resist. 2024, 2, 15. [Google Scholar] [CrossRef] [PubMed]
- McCubbin, K.D.; Barkema, H.W.; Babujee, A.; Forseille, J.; Naum, K.; Buote, P.; Dalton, D.; Checkley, S.L.; Lehman, K.; Morris, T.; et al. One Health and Antimicrobial Stewardship: Where to Go from Here? Can. Vet. J. 2022, 63, 198–200. [Google Scholar]
- Musoke, D.; Kitutu, F.E.; Mugisha, L.; Amir, S.; Brandish, C.; Ikhile, D.; Kajumbula, H.; Kizito, I.M.; Lubega, G.B.; Niyongabo, F.; et al. A One Health Approach to Strengthening Antimicrobial Stewardship in Wakiso District, Uganda. Antibiotics 2020, 9, 764. [Google Scholar] [CrossRef] [PubMed]
- Mannu, L.; Paba, A.; Daga, E.; Comunian, R.; Zanetti, S.; Duprè, I.; Sechi, L.A. Comparison of the Incidence of Virulence Determinants and Antibiotic Resistance between Enterococcus faecium Strains of Dairy, Animal and Clinical Origin. Int. J. Food Microbiol. 2003, 88, 291–304. [Google Scholar] [CrossRef]
- Ribeiro, T.; Oliveira, M.; Fraqueza, M.J.; Lauková, A.; Elias, M.; Tenreiro, R.; Barreto, A.S.; Semedo-Lemsaddek, T. Antibiotic resistance and virulence factors among Enterococci isolated from chouriço, a traditional Portuguese dry fermented sausage. J. Food Prot. 2013, 74, 465–469. [Google Scholar] [CrossRef]
- Bin-Asif, H.; Ali, S.A. The Genus Enterococcus and Its Associated Virulent Factors. In Microorganisms; IntechOpen: London, UK, 2019. [Google Scholar]
- Jiahui, W.; Dan, J.; Hehai, L.; Aihong, L.; Guiquan, G.; Jianxun, L.; Hong, Y.; Youquan, L. Detection of Virulence Genes and Antimicrobial Resistance in Enterococcus faecium. Chin. Vet. Sci. 2020, 50, 1428–1432. [Google Scholar]
Disclaimer/Publisher’s Note: The statements, opinions and data contained in all publications are solely those of the individual author(s) and contributor(s) and not of MDPI and/or the editor(s). MDPI and/or the editor(s) disclaim responsibility for any injury to people or property resulting from any ideas, methods, instructions or products referred to in the content. |
© 2025 by the authors. Licensee MDPI, Basel, Switzerland. This article is an open access article distributed under the terms and conditions of the Creative Commons Attribution (CC BY) license (https://creativecommons.org/licenses/by/4.0/).